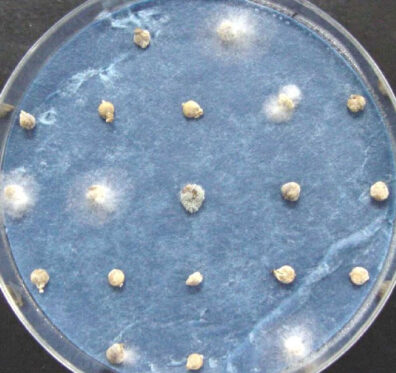
verticillium wilt of spinach seeds-5

Diseases
Insect/Mite Pests
Abiotic Problems
(Click on photo to enlarge)
Diseases
Anthracnose
Disease: Anthracnose
Latin binomial: Colletotrichum dematium (= Colletotrichum spinaciae, Colletotrichum dematium f. sp. spinaciae).
Host crops: Spinach
Online Resources:
- Spinach Diseases: Field Identification, Implications, & Management Practices (pdf) by Lindsey du Toit, Washington State University, presented on 23 May 2006 at the Organic Seed Alliance Spinach Seed Field Day.
- Biology and Management of Spinach Anthracnose (pdf). Oklahoma State University.
- Diseases of spinach ( Spinacia oleracea ) in Arizona: Anthracnose. The University of Arizona.
- HPIPM: Anthracnose Spinach. Bugwood Wiki.
- Spinach: Anthracnose. UC IPM Online, University of California.
Cladosporium leaf spot
Disease: Cladosporium leaf spot
Causal agent: Cladosporium variable
Online Resources:
- Pacific Northwest Plant Disease Management Handbook: Spinach (Spinacia oleracea) – Leaf Spot.
- Crop Profile for Spinach Seed in Washington (pdf).
Damping-off/Seedling blight
Disease: Damping-off/Seedling blight
Pathogen: Aphanomyces, Fusarium, Pythium, and Rhizoctonia species.
Host crops: Most vegetables are susceptible to damping-off/seedling blight including watermelon.
On-Line Resources:
- Pacific Northwest Plant Disease Management Handbook: Damping-off in Vegetable Seedlings.
- Common Diseases: Damping-off. Washington State University Hortsense.
- University of California IPM online page on spinach damping-off and root rot.
Downy Mildew
Disease: Downy Mildew
Pathogen: Peronospora farinosa f. sp. spinaciae
Online Resources:
- Pacific Northwest Plant Disease Management Handbook: Spinach (Spinacia oleracea) – Downy Mildew.
- UC Pest Management Guidelines: Spinach: Downy Mildew. UC IPM Online. University of California.
Fusarium wilt
Disease: Fusarium wilt
Pathogen: Fusarium oxysporum f. sp. spinaciae
Host crops: Spinach. Other crops can be asymptomatic hosts, e.g., beet and Swiss chard.

Photo Source: Lindsey du Toit, Washington State University
Online Resources:
- Effect of agricultural limestone amendment on Fusarium wilt and Verticillium wilt in a spinach seed crop, 2008 (pdf). Plant Disease Management Reports
- Evaluation of limestone amendments for control of Fusarium wilt in a spinach seed crop, 2006 (pdf). Plant Disease Management Reports
- Fusarium & Verticillium Wilts in Spinach: Research Update (pdf).
Stemphylium leaf spot
Disease: Stemphylium leaf spot
Causal agent: Stemphylium botryosum (asexual stage) (= Pleospora herbarum, sexual stage)
Online Resources:
- Pacific Northwest Plant Disease Management Handbook: Spinach (Spinacia oleracea) – Stemphylium Leaf Spot.
- Crop Profile for Spinach Seed in Washington (pdf).
Verticillium wilt
Disease: Verticillium wilt
Causal agent: Verticillium dahliae
Host crops: Numerous vegetables including many brassica vegetables (but not broccoli), cucumber,
eggplant, pepper, potato, pumpkin, radish, spinach, tomato, watermelon, etc.

Photo Source: Lindsey du Toit

Photo Source: Lindsey du Toit
Online Resources:
- Verticillium Wilt in Spinach Seed Production (pdf).
- Pacific Northwest Plant Disease Management Handbook: Spinach (Spinacia oleracea) – Verticillium Wilt.
- Crop Profile for Spinach Seed in Washington (pdf).
- See Diseases, pests, and other problems common to many vegetables: Verticillium wilt.
- Fusarium & Verticillium Wilts in Spinach: Research Update (pdf).
Insect/Mite Pests
Lygus bugs
Common name: Lygus bugs
Latin binomial: Lygus spp.
Host crops: Numerous different species of vegetables and other crops, e.g., alfalfa, beet, cabbage, carrot, spinach, Swiss chard, etc. Lygus bugs can cause different types of damage to various growth stages of different crops. They cause blackheart on celery, blasting on flower tissues, collapse of asparagus spears, decreased yields in carrot, beet, spinach, and other seed crops, etc.
Online Resources:
Spinach leafminer
Common name: Spinach leafminer
Latin binomial: Pegomya hyoscyami
Host crops: Spinach, beet, sugar beet, Swiss chard, and many weeds including lamb’s-quarters, chickweed, and nightshade.
Online Resources:
- Pacific Northwest Insect Management Handbook: Spinach – Leafminer.
- Spinach: Leafminers, UC IPM Online, University of California Agriculture & Natural Resources.
- Leafminers (vegetables), Wisconsin Horticulture, University of Wisconsin Cooperative Extension.
Spider mites
Common name: Spider mites
Latin binomial: Tetranychus spp. including twospotted spider mite (Tetranychus urticae), strawberry spider mite (Tetranychus turkestani), and Pacific spider mite (Tetranychus pacificus)
Host crops: Wide host range, including many vegetables such as bean, carrot seed crops, potato, etc.
On-Line Resources:
- Carrot seed – Twospotted spider mite. PNW Insect Management Handbook, Chapter: Vegetable Seed, Section: Carrot Seed.
- See Diseases, pests, and other problems common to many vegetables: Spider mites.
- Managing spider mites in gardens and landscapes. University of California Online Statewide Integrated Pest Management Program.
Springtails
Common name: Springtails (subterranean types)
Latin binomial: Order Collembola. There are numerous types of springtails or collembola, which are divided into two groups – subterranean springtails and surface springtails.
Host crops: Multiple vegetables, but most damage has been reported on spinach and beets, primarily in heavier, organic soils during very wet, cool spring conditions.

Photo Source: Lindsey du Toit, Washington State University

Photo Source: Lindsey du Toit, Washington State University
Online Resources:
- Springtails in Sugarbeet: Identification, Biology, and Management (pdf). North Dakota State University, Fargo.
- Control of Subterranean Springtails in Sugarbeet Using Granular, Liquid, and Seed Treatment Insecticides (pdf). North Dakota State University, Fargo.
- Springtail feeding on emerging crops (especially sugarbeet) (pdf). Michigan State University.
- Pest: Springtail. Pest Spotter, Bayer CropScience.
- Also, see Swiss Chard: Springtails.
Wireworm
Common name (of damaging stage): Wireworm (adults are called click beetles or snapping beetles)
Latin binomial: Ctenicera spp. and Limonius spp. Several kinds of wireworms are in the Pacific Northwest. Wireworms causing the most damage in irrigated areas are the Pacific Coast wireworm (Limonius canus), the sugar beet wireworm (L. californicus), the western field wireworm (L. infuscatus), and the Columbia Basin wireworm (L. subauratus). The Pacific Coast and sugar beet wireworms are the most common. Where annual rainfall is <15 inches, the Great Basin wireworm (Ctenicera pruinina) may be a problem, especially when irrigated crops are grown on sagebrush or dry wheat land. This species usually disappears after a few years of irrigation, but may be replaced by Limonius spp. which are favored by moist conditions. West of the Cascades, other wireworm species are pests, including Agriotes spp.
Host crops: All crops are susceptible to wireworm, but this pest is most destructive on beans, carrot, corn, grain, onion, potatoes, spinach seed crops, and other annual crops in the PNW.

Photo Source: Oregon State University –Oregon State Arthropod Collection.

Photo Source: Oregon State University – Oregon State Arthropod Collection.

Photo Source: Oregon State University – Oregon State Arthropod Collection.
Online Resources:
- Pacific NorthwestInsect Management Handbook: Vegetable crop pests – Wireworm.
- Wireworms VegEdge, University of Minnesota.
- Spinach: Wireworms. UC IPM Online, University of California.
- Wireworm Field Guide (pdf) – A guide to the identification and control of wireworms, Syngenta Crop Protection Canada, Inc.
- Managing Wireworms in Vegetable Crops. Ontario Ministry of Agriculture and Food.
- Wireworm Biology and Nonchemical Management in Potatoes in the Pacific Northwest, N. Andrews, M. Ambrosino, G. Fisher, and S.I. Rondon, Pacific Northwest Extension Publication no. PNW607.
- See Diseases, pests, and other problems common to many vegetables: Wireworm.
Abiotic Problems
Herbicide Injury
Problem: Clomazone (Command) herbicide residual carryover in spinach
Crops affected: Spinach and many other crops sensitive to clomazone develop symptoms of whitening of the foliage if planted too soon after an application of the herbicide clomazone (Command). It is very important to follow crop rotation intervals recommended on the label to avoid such injury.
Online Resources:
- Spinach: Integrated Weed Management. University of California IPM Pest Management Guidelines.
- Command® 3ME. Maufacturer’s product information page, FMC Corporation.
Edema
Common name: Edema
Cause: A physiological problem prominent when air is cooler than the soil, soil moisture is high, and relative humidity is high. The low plant transpiration rates combined with an increase in water absorption by roots from the soil leads to increased cell turgor pressure, resulting in eruption of epidermal cells as the inner cells enlarge. Protrusion of the inner cells causes epidermal cells to die and discolor, resulting in a ’warty’ appearance that can be misidentified as a disease. Symptoms are usually worse on the lower leaf surface and on older (lower) leaves.
Host Crops: Numerous vegetables including spinach, brassicas, tomato, etc. Vegetables with waxy leaves, e.g., brassicas, tend to be most susceptible.
Photo Source: Pop Vriend Seed Co.

Photo Source: Pop Vriend Seed Co., Holland

Photo Source: Pop Vriend Seed Co., Holland

Photo Source: Pop Vriend Seed Co., Holland
Online Resources:
- University of Delaware: Edema on Cole Crop Leaves.
- University of Massachusetts: Edema Spring Crops.
- What are these bumps on my vegetables? Edema or oedema: It doesn’t matter how you spell it, it still doesn’t look good. What is it, what causes it and how can I prevent it? Michigan State University Extension.
If you need the content provided on this site in an alternate format or for further information on the Vegetable Seed Pathology program,
please contact: Lindsey du Toit at dutoit@wsu.edu or at 360-848-6140.
Our pages provide links to external sites for the convenience of users. WSU Extension does not manage these external sites, nor does Extension review, control, or take responsibility for the content of these sites. These external sites do not implicitly or explicitly represent official positions and policies of WSU Extension.